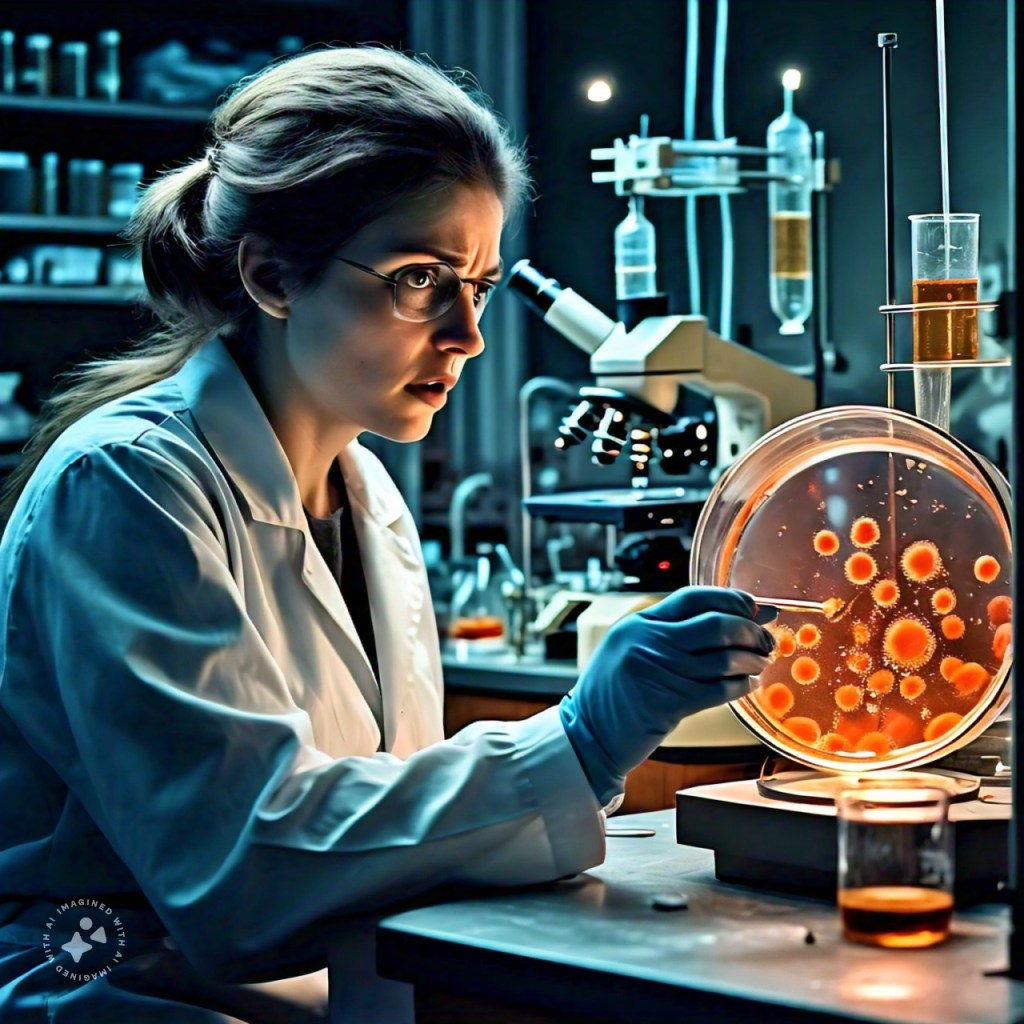
A stem cell dividing and growing into an uncontrolled mass or tumor, highlighting the potential risks of unregulated stem cell growth.

Stem cell research holds immense promise for revolutionizing medicine, but it also sails through choppy ethical seas. Here are the key concerns:

1. The Embryo Dilemma
Stem cells are often derived from human embryos, which sparks debate on the sanctity of human life. Some argue that embryos have the potential to become fully formed humans and should be treated with the same respect and rights. Others argue that embryos are just a cluster of cells and do not possess consciousness or the ability to feel pain.

2. Genetic Engineering
Stem cells can be used to create genetically engineered humans, which raises questions on the limits of scientific intervention. Some worry that genetic engineering could lead to a new form of eugenics, where certain traits or characteristics are deemed superior to others.

3. Human-Animal Chimeras
Stem cells can be used to create human-animal hybrids, which challenges our understanding of species boundaries. Some worry that these hybrids could possess human-like consciousness or abilities, leading to ethical concerns on their treatment and rights.

4. Reproductive Cloning
Stem cells can be used to clone humans, which sparks fears of a Brave New World scenario where humans are created and controlled. Some worry that cloning could lead to a loss of individuality and autonomy.
5. Tumor and Cancer Risks
Stem cells have the ability to proliferate and differentiate, which can also lead to uncontrolled growth and malignancies. Some worry that stem cells could cause tumors or cancer, particularly if they are not properly regulated.

6. Designer Babies
Stem cells can be used to select human traits, such as eye color or hair color, which raises concerns on the ethics of genetic selection. Some worry that this could lead to a form of genetic determinism, where certain traits are deemed superior to others.

7. Superhuman Enhancements
Stem cells can be used to create humans with extraordinary abilities, such as enhanced strength or intelligence. Some worry that this could lead to a new form of inequality, where those with enhancements possess an unfair advantage over those without.

8. Lifespan Extension
Stem cells can be used to extend human lifespan, which raises questions on the implications of prolonged human life. Some worry that this could lead to overpopulation, resource depletion, and social and economic disparities.
These ethical concerns highlight the need for ongoing discussions and guidelines to ensure responsible and ethical stem cell research practices. Researchers, policymakers, and the public must work together to address these concerns and ensure that stem cell research is conducted in a way that respects human dignity and promotes the greater good.

[…] What are the major ethical concerns in stem cell research? […]
LikeLike